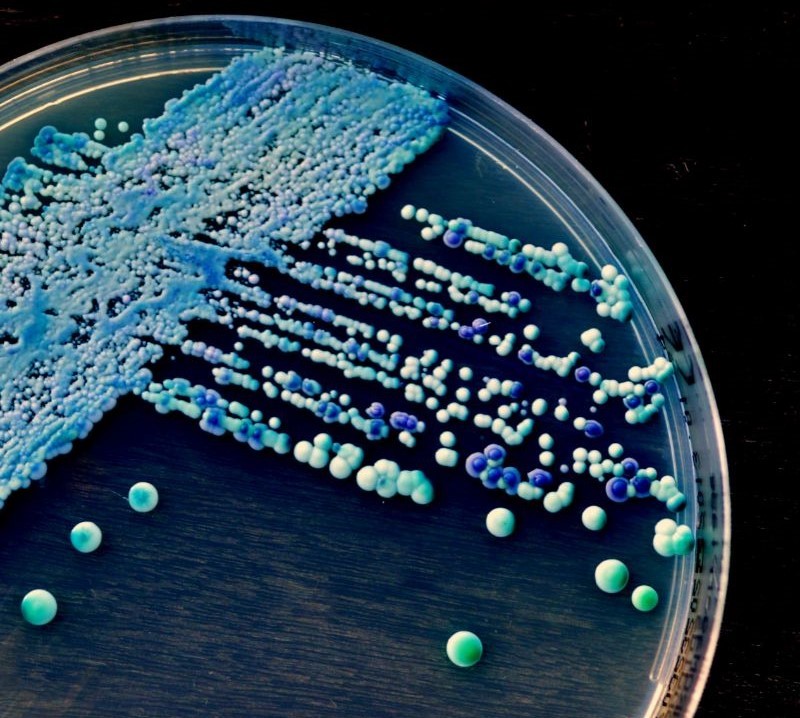

ValleyDAO Fuels the Future By Backing Sustainable Oil Production with Synthetic Biology
Groundbreaking research on sustainable oil production using engineered yeast receives substantial backing from ValleyDAO, marking a significant milestone in democratizing scientific research funding
Scharvik (Canva)
In a remarkable development for the synthetic biology sector, ValleyDAO has extended substantial financial support to Rodrigo Ledesma-Amaro, PhD—lecturer in the Department of Bioengineering at Imperial College London—for his pioneering work on engineering oleaginous yeast to produce oils sustainably at an industrial scale. This funding, facilitated via an IP-NFT, signifies a promising future for synthetic biology researchers seeking financial backing from ValleyDAO.

Dr. Amaro, a renowned leader in synthetic biology, has made significant contributions to the field, with over 100 scientific articles and five patents to his name. His work primarily focuses on metabolic engineering and microbial biotechnology.
"I saw the potential of microorganisms and their versatility to be engineered to produce, in a sustainable manner, everything we need and we currently make from petrochemicals (e.g., food ingredients) or damaging agricultural practices (e.g., palm oil)," said Dr. Amaro.
ValleyDAO, a recent graduate of the bio.xyz program, shares a common mission with Dr. Amaro: to leverage synthetic biology to address environmental and societal challenges. The organization has committed £228,000 to Dr. Amaro’s lab at Imperial College London, in exchange for a portion of the intellectual property produced, via their first IP-NFT.
"This model is more than just about funding. It allows us to publicly present our ideas and, if they resonate with the community, secure potential funding. In essence, ValleyDAO is democratizing how scientific research is perceived, valued, and supported," Dr. Amaro noted.
The funding will be directed towards Dr. Amaro's work on optimizing oil extraction from oleaginous yeast, a project that aligns perfectly with ValleyDAO's vision of supporting transformative scientific advancements for a sustainable and resilient future.
Lipids, commonly known as fats or oils, are essential in various industries, including food production, cosmetics, and fuel. Current practices of sourcing these lipids from animal and vegetable origins, such as palm oil harvesting, are unsustainable. Microbes offer a more sustainable alternative, albeit at a higher cost.
Dr. Amaro's research focuses on Yarrowia lipolytica, an oleaginous yeast species known for its high lipid accumulation. By bioengineering these yeasts, scientists can increase their oil yield, providing a sustainable source of fatty acids essential to the food industry.
The funds from ValleyDAO will be instrumental in improving the lipid harvesting process and exploring the possibility of a continuous fermentation process. If successful, lipid harvesting costs in Yarrowia lipolytica could be reduced by up to 70%.
ValleyDAO's innovative IP-NFT-based financing model ensures that the resulting Intellectual Property (IP) from a research project is governed by the ValleyDAO community using the DAO’s native governance token, GROW. This model fosters a more democratic IP-management strategy, encouraging the direct participation of synthetic biology enthusiasts in the funding and translation of a research project.
"ValleyDAO's ability to bridge the gap between science and the broader community fosters a genuine interest in, and support for, future discoveries," Dr. Amaro remarked.
ValleyDAO is keen to support academic research projects with up to $250k that have the potential to create a widespread climate, food, or environmental impact. If this aligns with your research, apply now by filling out this form.
Read More
Newletter & More

SynBioBeta
Join the innovators shaping the future with SynBio + AI. From health to ag, materials & more—be part of the revolution.















